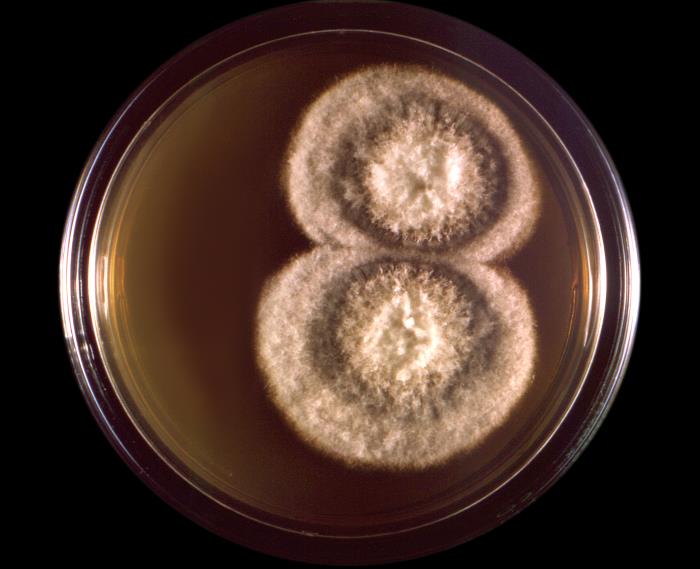
Colonia de Coccidioides immitis.

Coccidioides es un hongo filamentoso o micelial perteneciente al filo Ascomycota. Presenta un crecimiento dimórfico. Crece como hongo saprofito y filamentoso en el suelo, produciendo y liberando esporas asexuales, denominadas artroconidias o artrosporas, que son las formas infecciosas. En los tejidos y líquidos orgánicos del hospedador, las artroconidias crecen y se transforman en una forma denominada esférula, dentro de la cual se desarrollan endosporas infecciosas, que se liberan y dispersan en el tejido circundante o a través de la sangre y dan lugar a nuevas esférulas. Cuando las endosporas se liberan al exterior o al suelo, se desarrollan como hongo saprofito micelial.
Macroscópicamente las colonias de la forma micelial se visualizan en 4 o 5 días, aunque pueden aparecer incluso a los 16 días. Al principio la colonia es glabra y después va adquiriendo aspecto velloso y algodonoso, de color blanco grisáceo o amarillento, aunque también pueden desarrollar otros colores a medida que envejece. Las colonias jóvenes no tienen artroconidias, estas se van desarrollando a medida que la colonia envejece.
Microscópicamente las hifas son delgadas y septadas. Las artroconidias son rectangulares, con forma de tonel, tienen paredes gruesas, a menudo varios núcleos, un tamaño de 2 x 4 micras (μm) o 3 x 6 µm y se encuentran alternas a lo largo de la hifa, separadas unas de otras por células disyuntoras.
La esférulas presentes en los tejidos infectados son grandes, de 20-150 μm de diámetro, tienen una pared doble y gruesa y en su interior puede haber cientos de endosporas. Las endosporas tienen forma globular con un tamaño de 2-5 µm.
Viabilidad, propagación y transmisión
Reservorio
El suelo.
Hospedadores
Humanos, casi todos los mamíferos (principalmente perros) y algunos reptiles (serpientes).
Dosis Infectiva Mínima (DIM)
Se estima que puede ser de 1-10 artroconidias.
Supervivencia ambiental
Coccidioides se encuentra en suelos alcalinos y arenosos de climas semiáridos, en regiones con poca precipitación anual y con veranos secos y calurosos. En su forma micelial puede soportar temperaturas extremas y alta salinidad.
Las artroconidias son resistentes y pueden sobrevivir durante muchos meses o años en el suelo o en el polvo de superficies inanimadas (fómites).
Formas de resistencia
Artroconidias.
Mecanismo de propagación y transmisión
El mecanismo de dispersión y transmisión es principalmente a través de las artroconidias presentes en el polvo procedente del suelo y de materiales o superficies contaminadas.
La infección se produce principalmente por la inhalación y, en menor medida, por la inoculación parenteral de artroconidias.
Raramente se produce la transmisión de persona a persona, y de animales al hombre (zoonosis), porque las esférulas presentes en los tejidos infectados tienen poco riesgo de infección por exposición directa; además, debido a su gran tamaño, apenas pueden ser dispersadas por el aire. Sin embargo, se han documentado casos de transmisión por inhalación y por inoculación percutánea de endosporas, a través de lesiones o mordedura de animales con infección diseminada (8) y por trasplante de órganos.
Vías de entrada
Respiratoria. Parenteral.
Distribución geográfica
California y Arizona.
Efectos sobre la salud
Grupo de riesgo
3 A
(Ver Anexo II RD 664/1997 )Infección
Coccidioidomicosis, coccidiomicosis, enfermedad de las Posadas-Wernicke, fiebre del valle de San Joaquín o fiebre del desierto: es una infección pulmonar que en la mayoría de los casos, entorno al 60 %, es asintomática o muy leve, con síntomas similares a la gripe (de 2 a 6 semanas de duración), como tos, fiebre, mialgias, dolor de garganta, fatiga y dolor pleurítico en el pecho. Una vez superada la infección, el individuo se encuentra inmunizado de por vida.
Las personas sintomáticas suelen ser personas inmunodeprimidas (personas con SIDA, linfoma y trasplante de órganos), que tras un periodo de incubación de 1-3 semanas desarrollan un cuadro pulmonar con neumonía aguda (coccidioidomicosis aguda). En un 10-50 % de los casos, también aparecen erupciones cutáneas (coccidioidomicosis cutánea secundaria) como eritema nodoso, exantema agudo ("eritema tóxico"), eritema multiforme, síndrome de Sweet y dermatitis granulomatosa intersticial y dolor en las articulaciones (reumatismo del desierto).
La neumonía aguda puede convertirse, en un pequeño porcentaje de casos, en neumonía progresiva crónica (coccidioidomicosis progresiva o crónica), pudiendo aparecer nódulos y cavidades en los pulmones. Además, en el 1 % de los casos, después de semanas, meses o años de la infección primaria puede producirse la diseminación hematógena de la infección (coccidioidomicosis diseminada) de los pulmones a otros órganos como la piel, los ganglios linfáticos, los huesos, las articulaciones y, en un 30-50 %, a las meninges (meningitis). La meningitis suele ser letal sin tratamiento.
Efectos alérgicos (Ver Anexo II RD 664/1997 ) / (Ver Allergen )
La infección primaria puede presentar síntomas de hipersensibilidad o reacción alérgica (3).
Efectos tóxicos (Ver Anexo II RD 664/1997 )
No se han descrito
Efectos cancerígenos (Ver International Agency for Research On Cancer - IARC )
No se han descrito
Efectos en la maternidad
La transmisión por vía transplacentaria y perinatal por contacto con material infeccioso de la vagina en el momento del parto es extremadamente rara, la diseminación podría ser mediante la inhalación de líquido amniótico o desprendimiento placentario (2) (8).
La infección diseminada es más frecuente en mujeres embarazadas en el tercer trimestre (6). La coccidioidomicosis neonatal ocurre de forma muy rara (2).
Enfermedad
| CIE-10 | Nombre | Enfermedad de Declaración Obligatoria |
|---|---|---|
| B38 | Coccidioidomicosis | No |
Actividades laborales con riesgo
Clasificación Nacional de Actividades Económicas (CNAE)
| CNAE 2009 | Descripción |
|---|---|
| A0111 | Cultivo de cereales, distintos de arroz, leguminosas y oleaginosas |
| A0113 | Cultivo de hortalizas, raíces y tubérculos |
| A0114 | Cultivo de caña de azúcar |
| A0116 | Cultivo de plantas para fibras textiles |
| A0130 | Propagación de plantas |
| A0148 | Otras explotaciones de ganado |
| A0150 | Producción agrícola combinada con la producción ganadera |
| A0161 | Actividades de apoyo a la agricultura |
| A0162 | Actividades de apoyo a la ganadería |
| A0163 | Actividades de preparación posterior a la cosecha y tratamiento de semillas para reproducción |
| E3600 | Captación, depuración y distribución de agua |
| E3700 | Recogida y tratamiento de aguas residuales |
| E3811 | Recogida de residuos no peligrosos |
| F4211 | Construcción de carreteras y autopistas |
| F4212 | Construcción de vías férreas de superficie y subterráneas |
| F4213 | Construcción de puentes y túneles |
| F4221 | Construcción de redes para fluidos |
| F4291 | Obras hidráulicas |
| F4299 | Construcción de otros proyectos de ingeniería civil n.c.o.p. |
| F4312 | Preparación de terrenos |
| F4313 | Perforaciones y sondeos |
| N7210 | Investigación y desarrollo experimental en ciencias naturales y técnicas |
| O8130 | Actividades de jardinería |
| R8699 | Otras actividades sanitarias n.c.o.p. |
| S9122 | Actividades de sitios históricos y monumentos |
| T9630 | Pompas fúnebres y actividades relacionadas |
Clasificación Nacional de Ocupaciones (CNO)
| CNO 2011 | Descripción |
|---|---|
| 2421 | Biólogos, botánicos, zoólogos y afines |
| 2432 | Ingenieros en construcción y obra civil |
| 2454 | Ingenieros geógrafos y cartógrafos |
| 2462 | Ingenieros técnicos de obras públicas |
| 2483 | Ingenieros técnicos en topografía |
| 2821 | Sociólogos, geógrafos, antropólogos, arqueólogos y afines |
| 3122 | Técnicos en construcción |
| 3132 | Técnicos en instalaciones de tratamiento de residuos, de aguas y otros operadores en plantas similares |
| 3141 | Técnicos en ciencias biológicas (excepto en áreas sanitarias) |
| 3313 | Técnicos en anatomía patológica y citología |
| 3314 | Técnicos en laboratorio de diagnóstico clínico |
| 5892 | Empleados de pompas fúnebres y embalsamadores |
| 6110 | Trabajadores cualificados en actividades agrícolas (excepto en huertas, invernaderos, viveros y jardines) |
| 6120 | Trabajadores cualificados en huertas, invernaderos, viveros y jardines |
| 8331 | Operadores de maquinaria de movimientos de tierras y equipos similares |
| 9441 | Recogedores de residuos |
| 9511 | Peones agrícolas (excepto en huertas, invernaderos, viveros y jardines) |
| 9512 | Peones agrícolas en huertas, invernaderos, viveros y jardines |
| 9530 | Peones agropecuarios |
| 9601 | Peones de obras públicas |
| 9602 | Peones de la construcción de edificios |
| 9603 | Peones de la minería, canteras y otras industrias extractivas |
| 9811 | Peones del transporte de mercancías y descargadores |
Prevención y control
Desinfectantes
Lejía en dilución 1:10, peróxido de hidrógeno a una concentración mayor o igual al 6 %, compuestos fenólicos al 3 % con tiempos de contacto de más de 20 minutos.
Inactivación física
Las artroconidias se inactivan con calor húmedo a 120 ºC durante 15 minutos.
Antimicrobianos
Anfotericina B, azoles como itraconazol, fluconazol, ketoconazol y voriconazol.
Vacunación
No disponible
Medidas preventivas generales
Evitar procesos pulvígenos (utilizar procedimientos en húmedo); si no es posible, cerramiento o aislamiento de dichos procesos o disponer de un sistema de extracción localizada.
Diseño adecuado de los lugares y equipos de trabajo con superficies lisas de fácil limpieza y desinfección.
Adecuada ventilación de los locales.
Limpieza y desinfección de locales, instalaciones, equipos y herramientas, para evitar la acumulación de polvo.
Reducir el uso de herramientas cortantes o punzantes; en caso necesario, utilizarlas con las debidas protecciones y precauciones.
Adecuadas medidas de higiene: lavado de manos con agua y jabón al finalizar la jornada laboral, después de quitarse los guantes y tras el contacto con elementos contaminados. Limpieza y desinfección de cortes, arañazos o heridas en la piel, evitar el contacto de las mismas con elementos contamina-dos. Cubrir las heridas con apósitos estériles e impermeables. Utilizar ropa de trabajo y equipos de protección individual, en la medida de lo posible, resistentes a la perforación.
Precauciones en centros sanitarios
En hospitales, centros sanitarios y veterinarios, adoptar las Precauciones Estándar (7).
EPI
Protección respiratoria: mascarillas autofiltrantes preferiblemente FFP3 o máscaras con filtros P3 en tareas que puedan generar polvo.
Protección de las manos: guantes de protección frente a microorganismos y de cierta resistencia mecánica en caso de contacto o manipulación de materiales potencialmente infecciosos.
Protección ocular o facial: gafa de protección de montura universal en caso de riesgo de contacto accidental mano/guante contaminado-ojo, o pantalla de protección facial (símbolo de marcado en montura: 3) en caso de riesgo de exposición a salpicaduras, o gafa de protección de montura integral con hermeticidad frente a partículas (símbolo de marcado en montura: 4), en caso de riesgo de exposición a polvo.
Seguridad en laboratorio
Nivel de contención: 3
Los principales riesgos son la inhalación y la inoculación parenteral de artroconidias, y el contacto con las membranas mucosas.
Las muestras más peligrosas son los cultivos del hongo, las muestras de suelo de zonas endémicas (suroeste de los Estados Unidos) y especímenes o muestras biológicas procedentes del tracto respiratorio inferior, del líquido cefalorraquídeo, del esputo y de lesiones cutáneas y viscerales.
Se requieren las prácticas y la contención de un nivel 3 de bioseguridad para aquellas actividades que impliquen la manipulación de cultivos del hongo, muestras ambientales de suelo, especímenes clínicos y animales que estén o puedan estar infectados. Las actividades con hongos dimórficos se deben realizar en una cabina de seguridad biológica (CSB) u otro dispositivo de contención primaria apropiado en combinación con el equipo de protección personal. Además, se debe evitar el empleo de material cortante o punzante y se deben utilizar guantes impermeables y ropa de trabajo.
Bibliografía
- Acha, P. N., & Szyfres, B. (2001). Zoonosis y enfermedades transmisibles comunes al hombre y a los animales (3ª ed.): Volumen I. Bacteriosis y micosis. Organización Panamericana de la Salud.
- Labarca, M., Santos, J., Aragón, J., & Reyna, E. (2015). Coccidioidomicosis diseminada y embarazo. Reporte de un caso. Clínica e investigación en ginecología y obstetricia, 42(1), 38-40. DOI: 10.1016/j.gine.2013.08.003.
- Rubio, M. C., Gil, J., Benito, T. R., Ramírez de Ocáriz, I., & Navarro, M. (2007). Micosis más frecuentes en nuestro medio. En Guía práctica de identificación y diagnóstico en micología clínica (2ª ed.) (Capítulo 2). Revista Iberoamericana de Micología.
- Centers for Disease Control and Prevention (CDC). (2020). Biosafety in microbiological and biomedical laboratories (6th ed.).
- Institut National de Recherche et de Sécurité (INRS). (2023). Coccidioides immitis. BAse d'OBservation des Agents Biologiques (BAOBAB).
- Public Health Agency of Canada. (2011). Coccidioides spp. Pathogen Safety Data Sheets.
- Servicio Riojano de Salud. (2008). Precauciones de aislamiento en centros sanitarios.
- The Center for Food Security and Public Health (CFSPH). (2010). Coccidioidomicosis. CFSPH-Español: Fichas de las enfermedades.